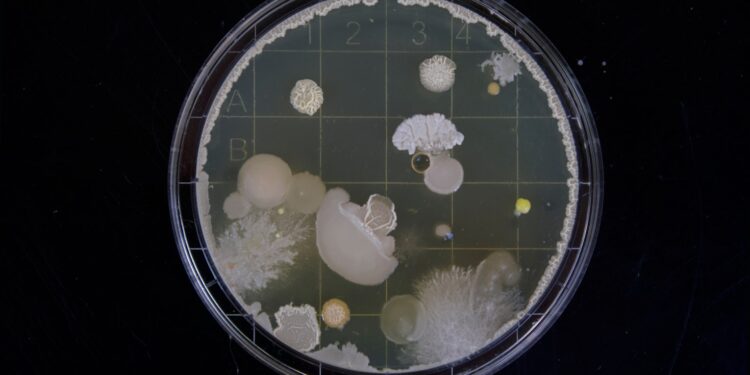

What experiment discovered the neutron?

Rutherford gold foil
Bohr model analysis
Chadwick’s experiment
Watson-Crick DNA study
Which study first confirmed the expanding universe?

Hubble’s galaxy study
Kepler’s planetary laws
Einstein’s theory of relativity
Newton’s law of gravitation
Who first measured the speed of light?

Galileo
Einstein
Ole Rømer
Newton
What did the Urey-Miller experiment simulate?

Origin of stars
Earth’s early atmosphere
Black hole formation
Solar system formation
What principle did the Stern-Gerlach experiment confirm?

Quantum entanglement
Quantum superposition
Quantum confinement
Quantum spin
The Galileo Thermoscope helped measure:

Air humidity
Air pressure
Temperature changes
Wind speed
Which study first confirmed the expanding universe?

Hubble’s galaxy study
Kepler’s planetary laws
Einstein’s theory of relativity
Newton’s law of gravitation
The Hershey-Chase experiments helped confirm that:

Proteins carry genetic information
DNA carries genetic information
Lipids form cell membranes
Carbohydrates provide energy
Who discovered radioactivity?

Marie Curie
Henri Becquerel
Ernest Rutherford
Niels Bohr
What did the Davisson-Germer experiment prove?

Wave-particle duality
Nuclear fusion
Photon emission
Radio wave propagation
Which experiment supported the big bang theory?

COBE satellite findings
Milikan oil drop
Galileo’s pendulum
Pavlov’s dogs
Who conducted the first controlled nuclear chain reaction?

Marie Curie
Albert Einstein
Enrico Fermi
Niels Bohr
What was the main discovery of the Millikan Oil Drop Experiment?

Structure of the atom
Existence of isotopes
Charge of an electron
Mass of a proton
What was demonstrated by the Foucault pendulum?

Earth rotates
Gravity is constant
Relativity of time
Solar energy
The discovery of penicillin was primarily accidental by:

Alexander Fleming
Louis Pasteur
Edward Jenner
Joseph Lister
What did Pavlov’s experiments with dogs demonstrate?

Genetic inheritance
Operant conditioning
Classical conditioning
Cognitive dissonance
Which experiment is known as the “double-slit experiment”?

Young’s experiment
Rutherford’s experiment
Mendel’s experiment
Millikan’s experiment
Rosalind Franklin contributed to understanding the structure of:

Proteins
DNA
Lipids
Carbohydrates
What was the purpose of the Michelson-Morley Experiment?

Detect Earth’s motion through space
Prove the existence of atoms
Discover the structure of DNA
Map the human genome
What phenomenon did the Geiger-Marsden experiment uncover?

Atomic nuclei
Electron clouds
Neutrino oscillations
Quantum tunneling

Just Scratching the Surface?
You’re at the starting line of scientific discovery!

Lab Apprentice
You’ve got the basics down; keep experimenting!

Master of the Scientific Method
Impressive! You’ve mastered the art of groundbreaking experiments!